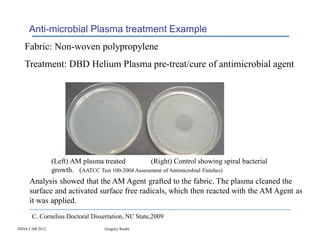
Anti-microbial Plasma treatment Example
   Fabric: Non-woven polypropylene
   Treatment: DBD Helium Plasma pre-treat/cure of antimicrobial agent




                (Left) AM plasma treated           (Right) Control showing spiral bacterial
                growth. (AATCC Test 100-2004 Assessment of Antimicrobial Finishes)
     Analysis showed that the AM Agent grafted to the fabric. The plasma cleaned the
     surface and activated surface free radicals, which then reacted with the AM Agent as
     it was applied.
      C. Cornelius Doctoral Dissertation, NC State,2009
INDA CAB 2012                     Gregory Roche

Recent Advances in Atmospheric Plasma Treatment of Textiles discusses how atmospheric plasma treatment is a new technology for surface finishing and pretreatments of textiles. It can be used on a wide range of materials, both woven and non-woven, and provides benefits like no waste water generation and effective processing costs. The document outlines different types of plasma equipment, examples of fabric treatments including cleaning and imparting hydrophilicity, and potential future applications of plasma treatment like adding functionality to fabrics.